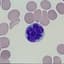
T-cell Lymphoma

Overview
- 🖥️ Steam ID
- 76561198000926497
- 22 Apr 2023 on Chimera OCE
- Total on servers
- 10 matches / 6 hours
- Matches
- Win rate
- Offense/defense score
- Combat/support score
Kills
- Total kills
- 125 (0.32 KPM)
- Kill types
- Total deaths
- 138 (0.35 DPM)
- Death types
- Overall K/D ratio
- 0.91
- Longest killstreak
- 13 kills on Chimera OCE (20 Feb 2024)
- Most deaths to artillery
- 5 deaths on Chimera OCE (22 Jan 2024)
Progression
Melee
- Melee kills
- 0 (N/A KD)
- Melee deaths
- 0
- N/A
- Current melee killstreak
- 0 melee kills (9 matches)
Recent matches played
- (0.16 kpm · 0.3 KD)
 Omaha Beach Warfare ()
Omaha Beach Warfare () - (0.11 kpm · 0.4 KD)
 Kursk Warfare (Night) ()
Kursk Warfare (Night) () - (0.83 kpm · 9.7 KD)
 Carentan Warfare ()
Carentan Warfare () - (0.25 kpm · 0.6 KD)
 St. Marie Du Mont Warfare ()
St. Marie Du Mont Warfare () - (0.15 kpm · 1.5 KD)
 Omaha Beach Warfare ()
Omaha Beach Warfare () - (1.11 kpm · 0.5 KD)
 Hurtgen Forest Warfare ()
Hurtgen Forest Warfare ()
Most kills matches
- (0.83 kpm · 9.7 KD)Most used: 37MM CANNON [Stuart M5A1]
 Carentan Warfare ()
Carentan Warfare () - (0.33 kpm · 0.8 KD)Most used: GEWEHR 43
 Purple Heart Lane Warfare (Night) ()
Purple Heart Lane Warfare (Night) () - (0.25 kpm · 0.6 KD)Most used: M1 GARAND
 St. Marie Du Mont Warfare ()
St. Marie Du Mont Warfare () - (0.37 kpm · 1.1 KD)Most used: M1 GARAND
 Carentan Warfare ()
Carentan Warfare () - (0.57 kpm · 0.9 KD)Most used: MG42
 St. Mere Eglise Warfare ()
St. Mere Eglise Warfare () - (0.16 kpm · 0.3 KD)Most used: M3 GREASE GUN
 Omaha Beach Warfare ()
Omaha Beach Warfare ()
Missing a match? Send us the CRCON scoreboard link on Discord and we'll add the server.
Most kills in one game
- Infantry
- 28 on Chimera OCE (22 Apr 2023)
- Machine Gun
- 9 on Chimera OCE (22 Apr 2023)
- Sniper
- N/A
- Armor
- 28 on Chimera OCE (20 Feb 2024)
- Artillery
- 5 on Chimera OCE (22 Apr 2023)
Loading most killed...
Most played with
Loading most played with...
Most played servers
See how you stack up against other players on the Chimera leaderboards.
Chimera leaderboards.
Most played game modes
- Warfare9
Weapon usage
| GEWEHR 43 | 24.80% 31 |
| M1 GARAND | 24.80% 31 |
| 37MM CANNON [Stuart M5A1] | 13.60% 17 |
| COAXIAL M1919 [Stuart M5A1] | 7.20% 9 |
| MG42 | 6.40% 8 |